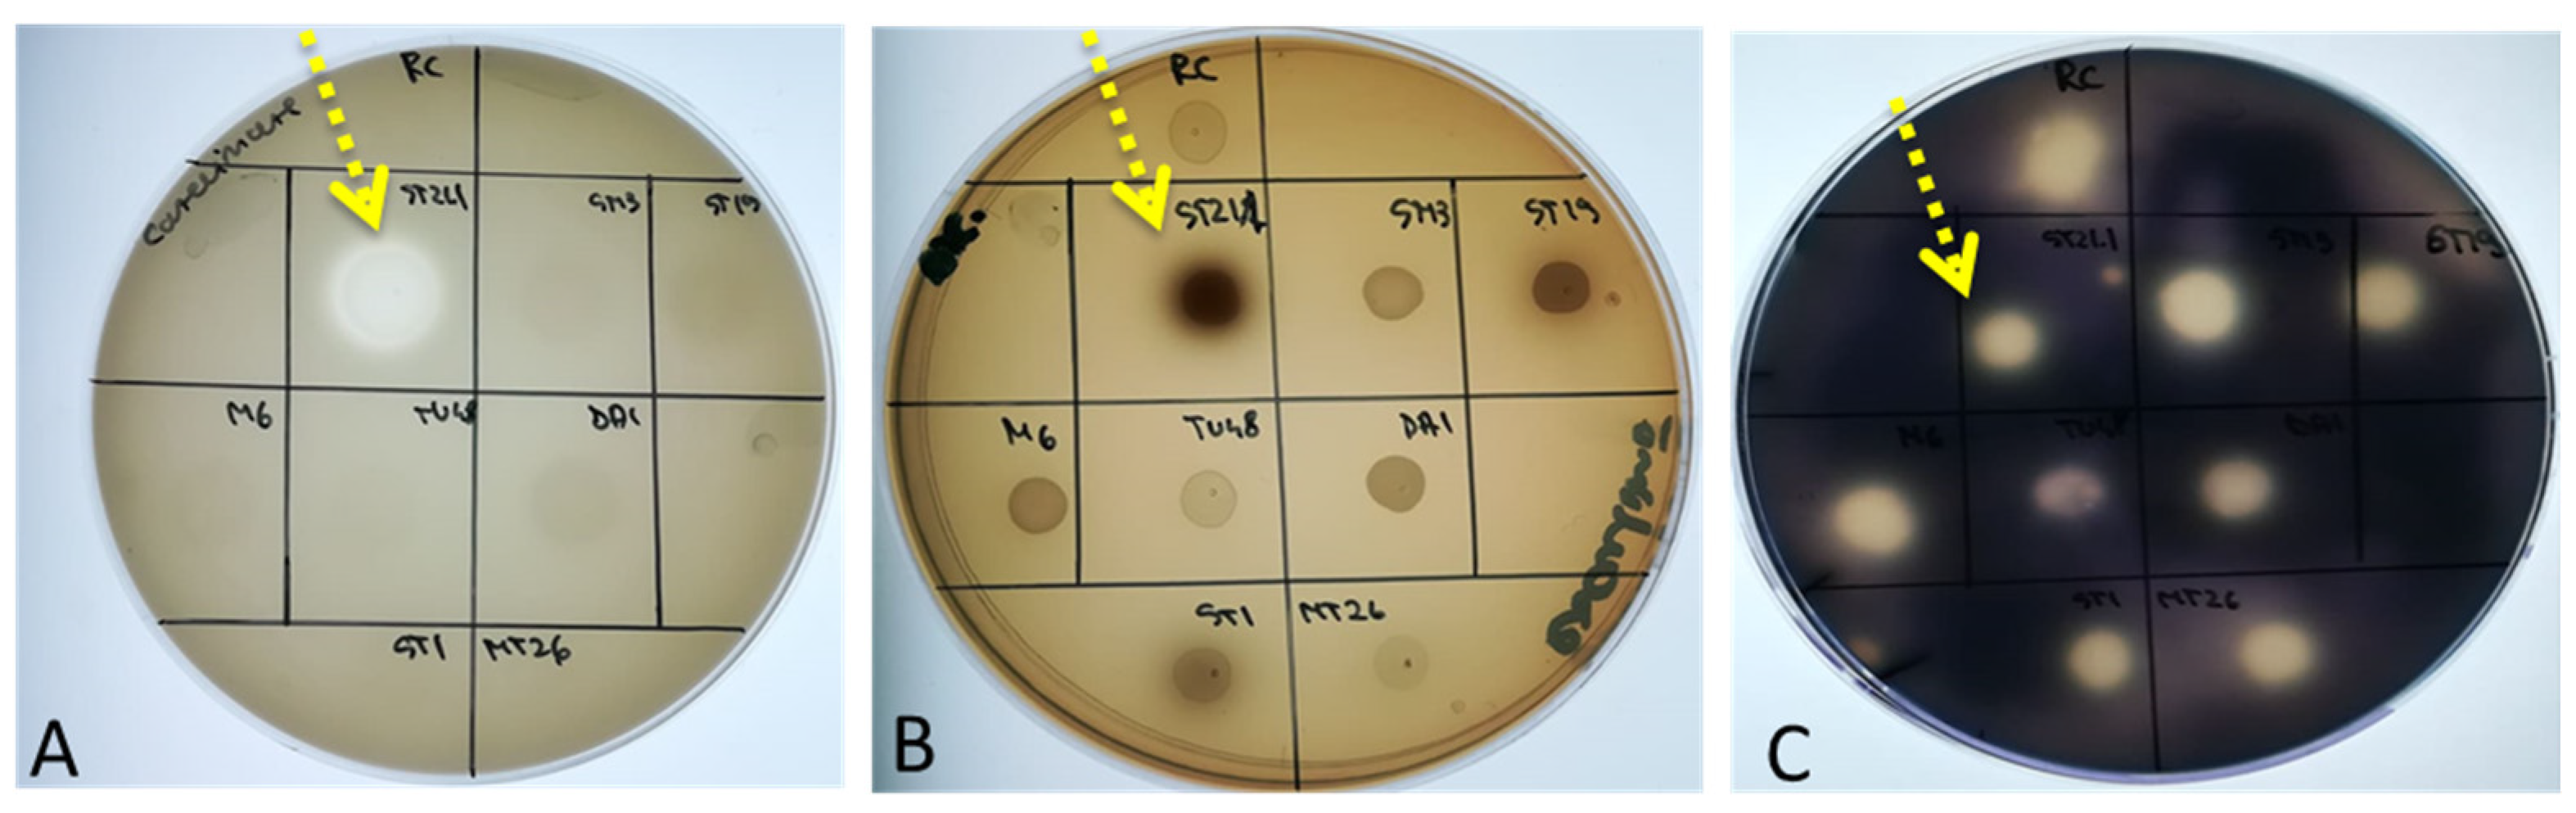
Life 14 01087 g001
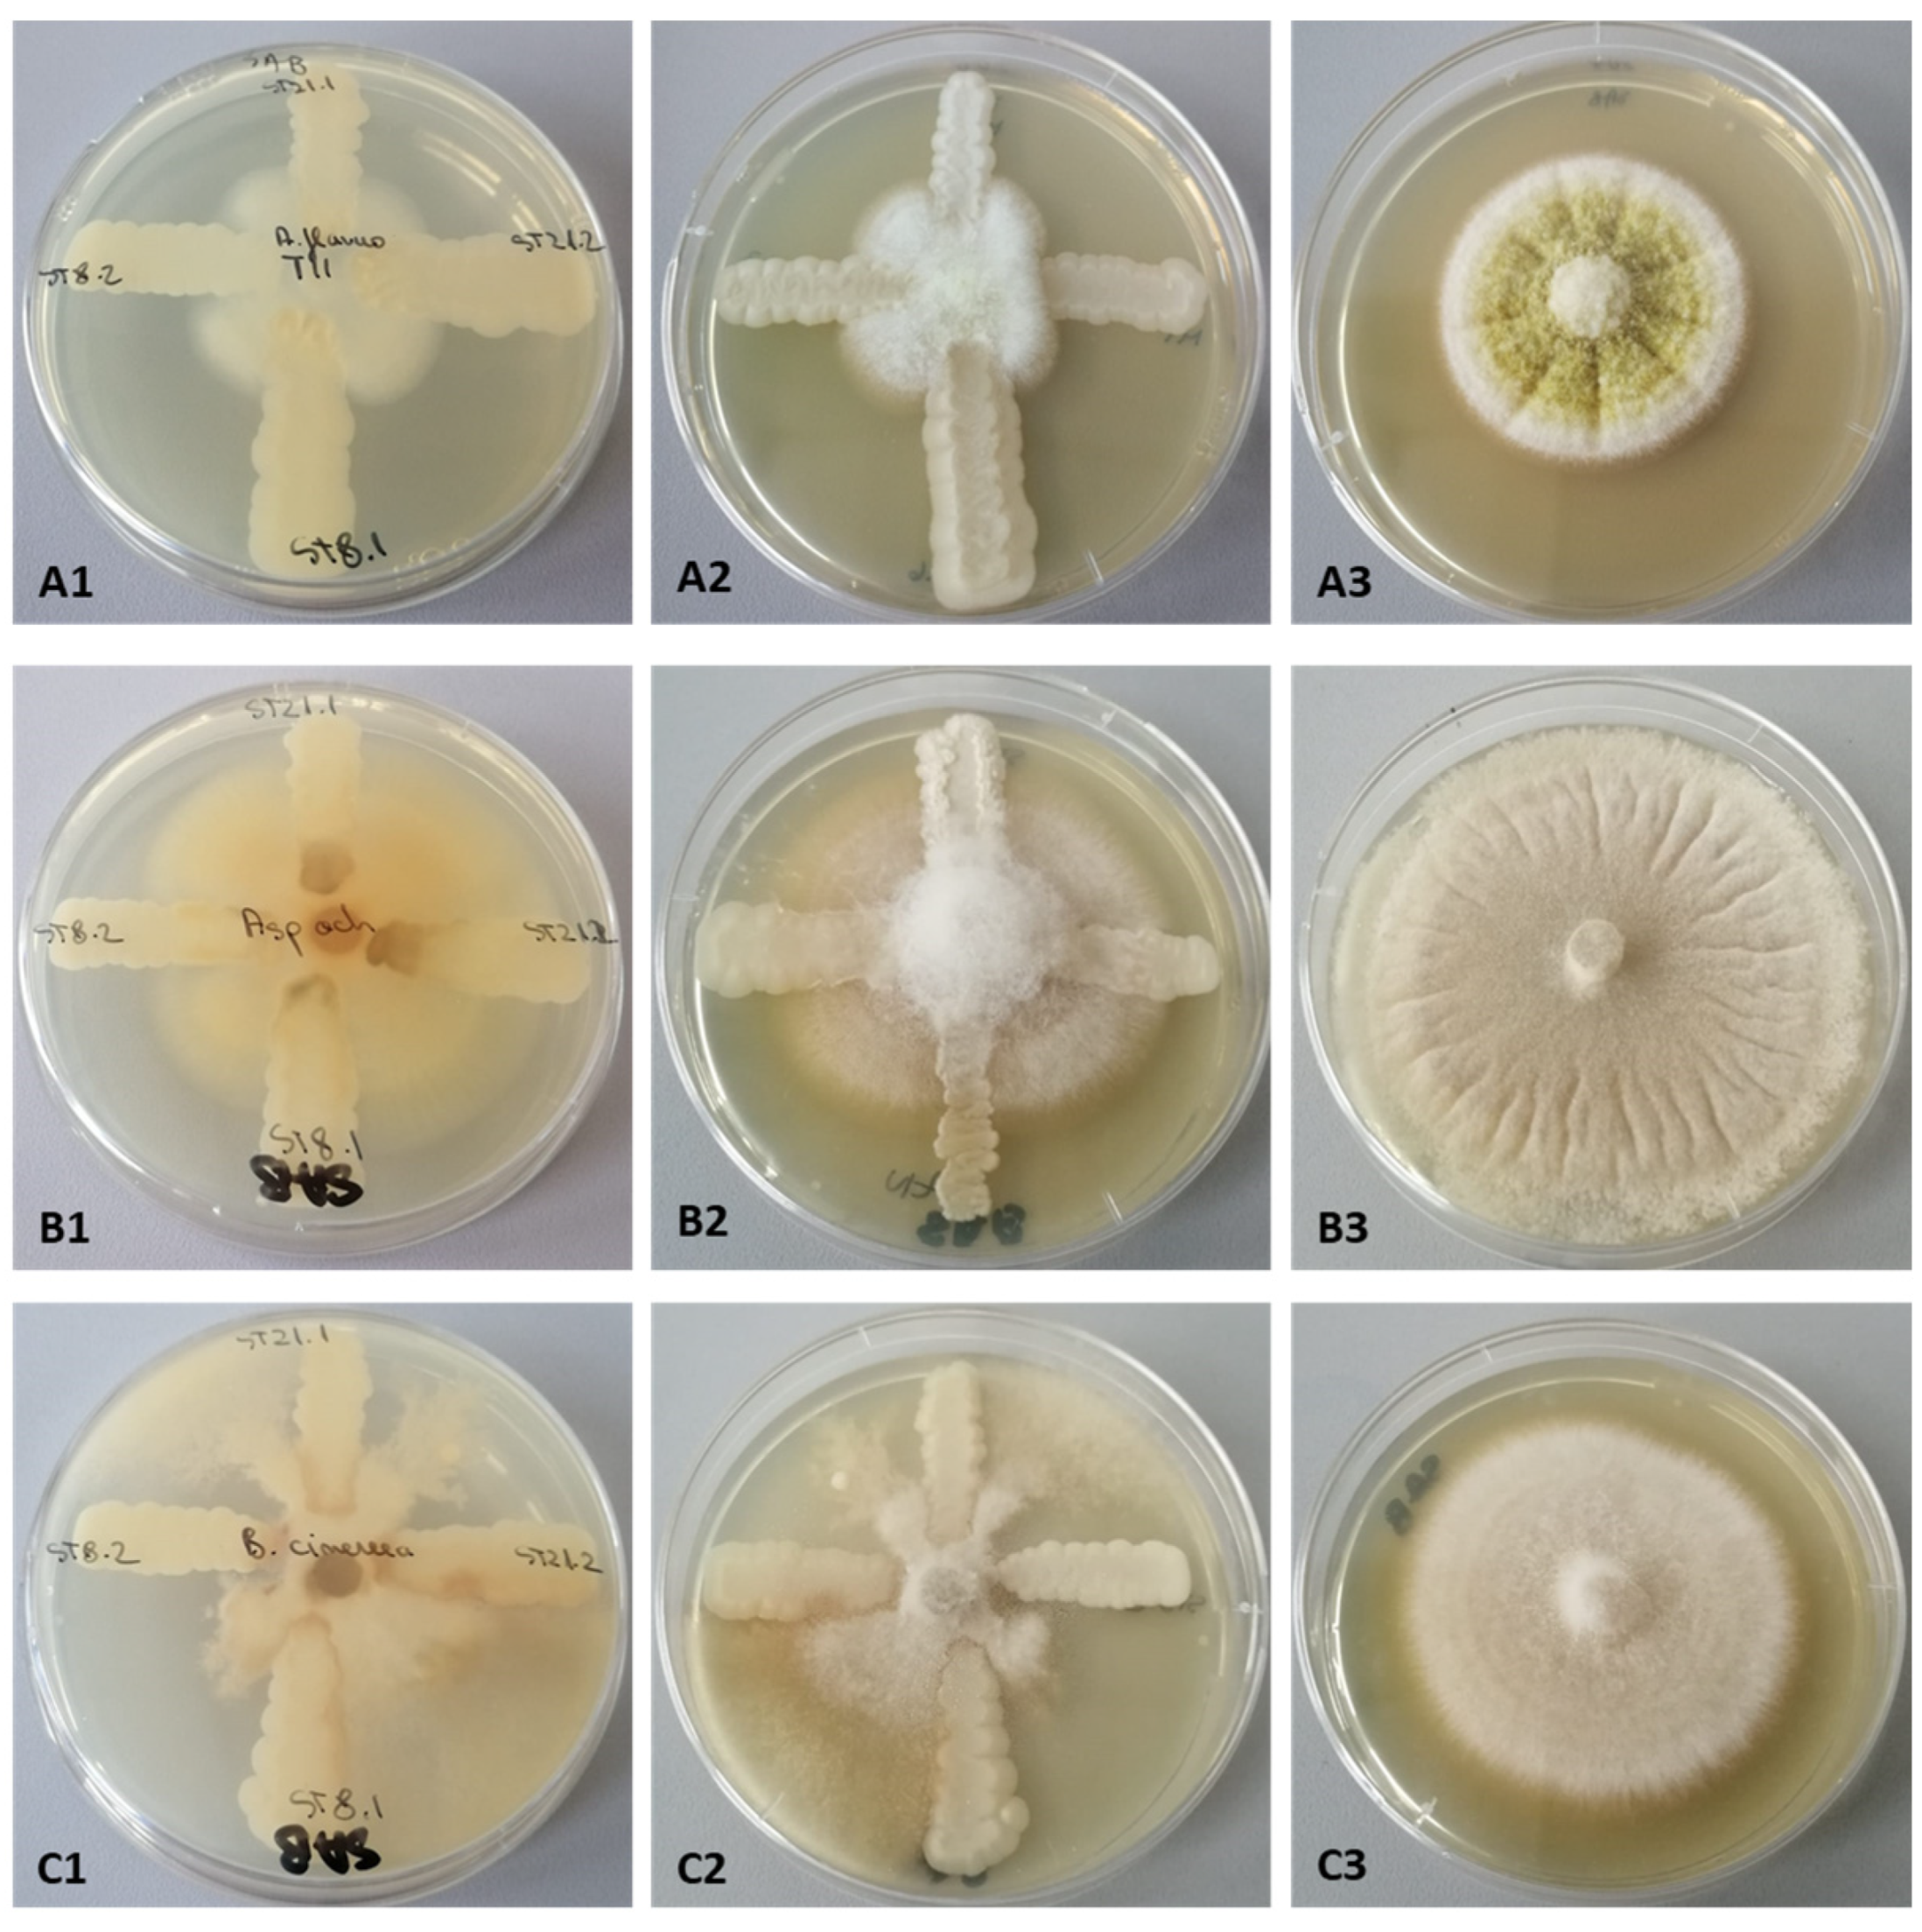
Life 14 01087 g006

Epiphytic Yeasts from South Romania for Preventing Food Microbial Contamination
Abstract
1. Introduction
2. Materials and Methods
2.1. Biological Material
2.2. Taxonomic Confirmation of Yeast Strains Using Automated Systems and Molecular Analyses
2.2.1. Taxonomic Identification Using the Biolog YT MicroPlates System (Biolog Inc., Hayward, CA, USA)
2.2.2. Taxonomic Identification Using the Bruker MALDI-TOF (Matrix-Assisted Laser Desorption/Ionization–Time of Flight) Identification System (Bruker Corporation, 40 Manning Road, Billerica, MA, USA)
2.2.3. Molecular Taxonomy Identification Based on ITS1-5.8S rDNA-ITS2 Coding Region
2.3. Confirmation of Safe Status
2.3.1. Production of Hydrolytic Enzymes
2.3.2. Cellular Dimorphism Assays
2.3.3. Adherence Capacity to Inert Substratum
2.4. Cell Growth under Stress Conditions
2.5. Qualitative Screening of Antimicrobial Activity
2.5.1. Anti-Candida Activity
Anti-Candida Activity Based on Competition for Nutritive Substrates
Anti-Candida Activity at Low pH Values
2.5.2. Anti-Bacterial Activity
2.5.3. Preliminary Assessment of the Probiotic Potential of Yeast Strains
Lipolytic Capacity Screening Assays on Tributyrin Medium
Antimicrobial Activity against Probiotic Microorganisms
2.5.4. Anti-Filamentous Fungi Activity
Qualitative Screening Tests for Antifungal Activity
Determining the Antifungal Effect of Yeasts by Co-Cultivation with Aspergillus flavus and Aspergillus ochraceus Fungi
2.6. Statistical Analysis
3. Results and Discussion
3.1. Complete Taxonomic Identification of Selected Yeast Strains
3.2. Non-Pathogenic Character of the Yeast Strains
3.3. Yeasts Resistance to Stress Conditions
3.3.1. Influence of Thermal Stress on Biomass Accumulation
3.3.2. Influence of Ionic and Osmotic Stress on Biomass Accumulation
3.4. Antimicrobial Activity of Epiphytic Yeasts
3.4.1. Anti-Candida Potential
3.4.2. Anti-Bacterial Potential
3.4.3. Practical Applications for Developing Probiotic Products
3.5. Epiphytic Yeasts as Biocontrol Agents
4. Conclusions
Supplementary Materials
Author Contributions
Funding
Institutional Review Board Statement
Informed Consent Statement
Data Availability Statement
Conflicts of Interest
References
- Thompson, C.; Ortmann, A.C.; Bolhuis, H.; Makhalanyane, T.; Thompson, F. Harnessing Marine Microbiomes to Develop a Sustainable, all-Atlantic Bioeconomy. mLife 2024, 3, 163–166. [Google Scholar] [CrossRef]
- Tsarelunga, A.A.; Blagoveschenskaya, E.Y. Phylloplane as Fungi Habitat. Biol. Bull. Rev. 2024, 14, 271–285. [Google Scholar] [CrossRef]
- Alfonzo, A.; Sicard, D.; Miceli, G.; Guezenec, S.; Settanni, L. Ecology of Yeasts Associated with Kernels of Several Durum Wheat Genotypes and Their Role in Co-Culture with Saccharomyces cerevisiae during Dough Leavening. Food Microbiol. 2021, 94, 103666. [Google Scholar] [CrossRef] [PubMed]
- Thomas, G.; Kay, W.T.; Fones, H.N. Life on a Leaf: The Epiphyte to Pathogen Continuum and Interplay in the Phyllosphere. BMC Biol. 2024, 22, 168. [Google Scholar] [CrossRef] [PubMed]
- Nasanit, R.; Jaibangyang, S.; Tantirungkij, M.; Limtong, S. Yeast Diversity and Novel Yeast D1/D2 Sequences from Corn Phylloplane Obtained by a Culture-Independent Approach. Antonie Leeuwenhoek 2016, 109, 1615–1634. [Google Scholar] [CrossRef] [PubMed]
- Debode, J.; Van Hemelrijck, W.; Creemers, P.; Maes, M. Effect of Fungicides on Epiphytic Yeasts Associated with Strawberry. MicrobiologyOpen 2013, 2, 482–491. [Google Scholar] [CrossRef]
- Yang, H.; Wang, L.; Li, S.; Gao, X.; Wu, N.; Zhao, Y.; Sun, W. Control of Postharvest Grey Spot Rot of Loquat Fruit with Metschnikowia pulcherrima E1 and Potential Mechanisms of Action. Biol. Control 2021, 152, 104406. [Google Scholar] [CrossRef]
- Parafati, L.; Vitale, A.; Restuccia, C.; Cirvilleri, G. Biocontrol Ability and Action Mechanism of Food-Isolated Yeast Strains against Botrytis cinerea Causing Post-Harvest Bunch Rot of Table Grape. Food Microbiol. 2015, 47, 85–92. [Google Scholar] [CrossRef]
- Herrera, C.M. Population Growth of the Floricolous Yeast Metschnikowia reukaufii: Effects of Nectar Host, Yeast Genotype, and Host × Genotype Interaction. FEMS Microbiol. Ecol. 2014, 88, 250–257. [Google Scholar] [CrossRef]
- Álvarez-Pérez, S.; Dhami, M.K.; Pozo, M.I.; Crauwels, S.; Verstrepen, K.J.; Herrera, C.M.; Lievens, B.; Jacquemyn, H. Genetic Admixture Increases Phenotypic Diversity in the Nectar Yeast Metschnikowia reukaufii. Fungal Ecol. 2021, 49, 101016. [Google Scholar] [CrossRef]
- Garcia-Gonzalez, M.; Narmontaite, E.; Cervantes, F.V.; Plou, F.J.; Betancor, L.; Fernandez-Lobato, M. Continuous Production of Honey Oligosaccharides in Packed-Bed Reactors with Immobilized α-Glucosidase from Metschnikowia reukaufii. Biocatal. Agric. Biotechnol. 2023, 47, 102590. [Google Scholar] [CrossRef]
- Garcia-Gonzalez, M.; Plou, F.J.; Cervantes, F.V.; Remacha, M.; Poveda, A.; Jiménez-Barbero, J.; Fernandez-Lobato, M. Efficient Production of Isomelezitose by a Glucosyltransferase Activity in Metschnikowia reukaufii Cell Extracts. Microb. Biotechnol. 2019, 12, 1274–1285. [Google Scholar] [CrossRef]
- Alakeji, T.P.; Banwo, K.; Ogunremi, O.R.; Sanni, A.I. Functional properties of yeasts isolated from some nigerian traditional fermented foods. J. Microbiol. Biotech. Food Sci. 2015, 4, 437–441. [Google Scholar] [CrossRef]
- Corbu, V.M.; Georgescu, A.M.; Gheorghe-Barbu, I.; Csutak, O. Antifungal activity of microbial strains isolated from romanian spontaneously fermented dairy products. AgroLife Sci. J. 2024, 13, 54–64. [Google Scholar] [CrossRef]
- Suzuki, M.; Nakase, T.; Daengsubha, W.; Chaowsangket, M.; Suyanandana, P.; Komagata, K. Identification of Yeasts Isolated from Fermented Foods and Related Materials in Thailand. J. Gen. Appl. Microbiol. 1987, 33, 205–219. [Google Scholar] [CrossRef]
- Suzana, C.S.M.; Viviane, O.A.; Claudia, M.M. Pichia Spp. Yeasts from Brazilian Industrial Wastewaters: Physiological Characterization and Potential for Petroleum Hydrocarbon Utilization and Biosurfactant Production. Afr. J. Microbiol. Res. 2014, 8, 664–672. [Google Scholar] [CrossRef]
- Zhang, J.; Liu, J.; Xie, J.; Deng, L.; Yao, S.; Zeng, K. Biocontrol Efficacy of Pichia membranaefaciens and Kloeckera apiculata against Monilinia fructicola and Their Ability to Induce Phenylpropanoid Pathway in Plum Fruit. Biol. Control 2019, 129, 83–91. [Google Scholar] [CrossRef]
- Zhao, Y.; Deng, L.; Zhou, Y.; Yao, S.; Zeng, K. Chitosan and Pichia membranaefaciens Control Anthracnose by Maintaining Cell Structural Integrity of Citrus Fruit. Biol. Control 2018, 124, 92–99. [Google Scholar] [CrossRef]
- Ahmadi, F.; Najafpour, G.D.; Mohammadi, M. Production of Bio-Fungicide from Sugarcane Bagasse Using Pichia membranifaciens Yeast and Its Activity against Post-Harvest Pathogenic Fungi. Biointerface Res. Appl. Chem. 2020, 11, 10435–10445. [Google Scholar] [CrossRef]
- Czarnecka, M.; Żarowska, B.; Połomska, X.; Restuccia, C.; Cirvilleri, G. Role of Biocontrol Yeasts Debaryomyces hansenii and Wickerhamomyces anomalus in Plants’ Defence Mechanisms against Monilinia fructicola in Apple Fruits. Food Microbiol. 2019, 83, 1–8. [Google Scholar] [CrossRef]
- Iacumin, L.; Arnoldi, M.; Comi, G. Effect of a Debaryomyces hansenii and Lactobacillus buchneri Starter Culture on Aspergillus westerdijkiae Ochratoxin A Production and Growth during the Manufacture of Short Seasoned Dry-Cured Ham. Microorganisms 2020, 8, 1623. [Google Scholar] [CrossRef]
- Islam, F.; Salam, M.A.; Rahman, M.d.A.; Paul, S.I.; Das, T.R.; Rahman, M.d.M.; Shaha, D.C.; Gupta, D.R.; Alam, M.S.; Islam, T. Plant Endophytic Yeasts Pichia fermentans and Meyerozyma caribbica Improve Growth, Biochemical Composition, Haematological Parameters and Morphology of Internal Organs of Premature Barbonymus gonionotus. Aquac. Rep. 2021, 19, 100575. [Google Scholar] [CrossRef]
- Arevalo-Villena, M.; Briones-Perez, A.; Corbo, M.r.; Sinigaglia, M.; Bevilacqua, A. Biotechnological Application of Yeasts in Food Science: Starter Cultures, Probiotics and Enzyme Production. J. Appl. Microbiol. 2017, 123, 1360–1372. [Google Scholar] [CrossRef] [PubMed]
- Muccilli, S.; Restuccia, C. Bioprotective Role of Yeasts. Microorganisms 2015, 3, 588–611. [Google Scholar] [CrossRef] [PubMed]
- Agarbati, A.; Canonico, L.; Marini, E.; Zannini, E.; Ciani, M.; Comitini, F. Potential Probiotic Yeasts Sourced from Natural Environmental and Spontaneous Processed Foods. Foods 2020, 9, 287. [Google Scholar] [CrossRef]
- Agustini, B.C.; Silva, L.P.; Bloch, C.; Bonfim, T.M.; Silva, G.A. Evaluation of MALDI-TOF Mass Spectrometry for Identification of Environmental Yeasts and Development of Supplementary Database. Appl. Microbiol. Biotechnol. 2014, 98, 5645–5654. [Google Scholar] [CrossRef] [PubMed]
- Ionescu, D.; Chifiriuc, M.C.; Ionescu, B.; Cristea, V.C.; Sacagiu, B.; Duta, M.; Neacsu, G.; Gilca, R.; Bleotu, C.; Bezirtzoglu, E.; et al. Frequency and Phenotypic Virulence Features of Streptococcus pyogenes Strains Isolated from Throat Carriage in Romanian Population. Rom. Biotechnol. Lett. 2015, 20, 10470–10477. [Google Scholar]
- Csutak, O.; Vassu, T. Phylogenetic Analysis and Characterization of an Alkane-Degrading Yeast Strain Isolated from Oil-Polluted Soil. Turk. J. Biol. 2014, 38, 601–610. [Google Scholar] [CrossRef]
- Pavel, A.B.; Vasile, C.I. PyElph—A Software Tool for Gel Images Analysis and Phylogenetics. BMC Bioinform. 2012, 13, 9. [Google Scholar] [CrossRef]
- BLAST: Basic Local Alignment Search Tool. Available online: https://blast.ncbi.nlm.nih.gov/Blast.cgi (accessed on 15 August 2024).
- Corbu, V.M.; Csutak, O. Molecular and Physiological Diversity of Indigenous Yeasts Isolated from Spontaneously Fermented Wine Wort from Ilfov County, Romania. Microorganisms 2023, 11, 37. [Google Scholar] [CrossRef]
- Zajc, J.; Gostinčar, C.; Černoša, A.; Gunde-Cimerman, N. Stress-Tolerant Yeasts: Opportunistic Pathogenicity Versus Biocontrol Potential. Genes 2019, 10, 42. [Google Scholar] [CrossRef] [PubMed]
- Avram, I.; Pelinescu, D.; Stoica, I.; Marutescu, L.; Vassu, T. Phenotypic Profiles of Virulence in Different Candida Species Isolated from Vulvovaginal Infections. Roum. Arch. Microbiol. Immunol. 2013, 72, 225–233. [Google Scholar]
- Jin, Y.; Yip, H.K.; Samaranayake, Y.H.; Yau, J.Y.; Samaranayake, L.P. Biofilm-Forming Ability of Candida albicans Is Unlikely To Contribute to High Levels of Oral Yeast Carriage in Cases of Human Immunodeficiency Virus Infection. J. Clin. Microbiol. 2003, 41, 2961. [Google Scholar] [CrossRef]
- Corbu, V.; Petrut, S.; Vassu, T.; Pelinescu, D.; Sarbu, I.; Rusu, E.; Csutak, O. Environmental Stress Responses in Yeasts and Lactic Acid Bacteria Strains Isolated from Dairy Traditional Romanian Fermented Products. Rom. Biotechnol. Lett. 2021, 26, 2548–2559. [Google Scholar] [CrossRef]
- Csutak, O.; Vassu, T.; Sarbu, I.; Stoica, I.; Cornea, P. Antagonistic Activity of Three Newly Isolated Yeast Strains from the Surface of Fruits. Food Technol. Biotechnol. 2013, 51, 70–77. [Google Scholar]
- Csutak, O.; Vassu, T.; Corbu, V.; Cîrpici, I.; Ionescu, R. Killer activity of Pichia anomala CMGB 88. Biointerface Res. Appl. Chem. 2017, 7, 2085–2089. [Google Scholar]
- Acuña-Fontecilla, A.; Silva-Moreno, E.; Ganga, M.A.; Godoy, L. Evaluation of Antimicrobial Activity from Native Wine Yeast against Food Industry Pathogenic Microorganisms. CyTA-J. Food 2017, 15, 457–465. [Google Scholar] [CrossRef]
- Marie, K.P.; Ngoufack François, Z.; Edith Marius, F.K.; Ciobotaru, O.; Matei, F.; Cornea, C.P.; Israel-Roming, F. Antifungal Activity of Lactic Acid Bacteria Isolated from Peanuts, Gari, and Orange Fruit Juice against Food Aflatoxigenic Molds. Food Biotechnol. 2018, 32, 237–256. [Google Scholar] [CrossRef]
- Corbu, V.; Csutak, O. Screening of Newly Isolated Yeast Strains Showing No Pathogenic Profile for Biotechnological Applications. In Proceedings of the Book of Abstracts, FEMS, Online, 28 October 2020; p. 38. [Google Scholar]
- Corbu, V. Obtaining and Characterizing a Mini Collection of Yeasts with Biotechnological Applications 2021. Ph.D. Thesis, University of Bucharest, Bucharest, Romania.
- Kačániová, M.; Kunová, S.; Sabo, J.; Ivanišová, E.; Žiarovská, J.; Felsöciová, S.; Terentjeva, M. Identification of Yeasts with Mass Spectrometry during Wine Production. Fermentation 2020, 6, 5. [Google Scholar] [CrossRef]
- Kurtzman, C.P.; Fell, J.W.; Boekhout, T. The Yeasts: A Taxonomic Study; Elsevier: Amsterdam, The Netherlands, 2011. [Google Scholar]
- Arroyo-López, F.N.; Durán-Quintana, M.C.; Ruiz-Barba, J.L.; Querol, A.; Garrido-Fernández, A. Use of Molecular Methods for the Identification of Yeast Associated with Table Olives. Food Microbiol. 2006, 23, 791–796. [Google Scholar] [CrossRef]
- Pham, T.; Wimalasena, T.; Box, W.G.; Koivuranta, K.; Storgårds, E.; Smart, K.A.; Gibson, B.R. Evaluation of ITS PCR and RFLP for Differentiation and Identification of Brewing Yeast and Brewery “wild” Yeast Contaminants. J. Inst. Brew. 2011, 117, 556–568. [Google Scholar] [CrossRef]
- Esteve-Zarzoso, B.; Belloch, C.; Uruburu, F.; Querol, A. Identification of Yeasts by RFLP Analysis of the 5.8S rRNA Gene and the Two Ribosomal Internal Transcribed Spacers. Int. J. Syst. Bacteriol. 1999, 49, 329–337. [Google Scholar] [CrossRef]
- Basílio, A.C.M.; De Araújo, P.R.L.; De Morais, J.O.F.; Da Silva Filho, E.A.; De Morais, M.A.; Simões, D.A. Detection and Identification of Wild Yeast Contaminants of the Industrial Fuel Ethanol Fermentation Process. Curr. Microbiol. 2008, 56, 322–326. [Google Scholar] [CrossRef] [PubMed]
- Villa-Carvajal, M.; Querol, A.; Belloch, C. Identification of Species in the Genus Pichia by Restriction of the Internal Transcribed Spacers (ITS1 and ITS2) and the 5.8S Ribosomal DNA Gene. Antonie Leeuwenhoek 2006, 90, 171–181. [Google Scholar] [CrossRef] [PubMed]
- Morata, A.; Loira, I.; Tesfaye, W.; Bañuelos, M.A.; González, C.; Suárez Lepe, J.A. Lachancea thermotolerans applications in wine technology. Fermentation 2018, 4, 53. [Google Scholar] [CrossRef]
- Xue, C.; Tada, Y.; Dong, X.; Heitman, J. The Human Fungal Pathogen Cryptococcus Can Complete Its Sexual Cycle during a Pathogenic Association with Plants. Cell Host Microbe 2007, 1, 263–273. [Google Scholar] [CrossRef]
- Opulente, D.A.; Langdon, Q.K.; Buh, K.V.; Haase, M.A.B.; Sylvester, K.; Moriarty, R.V.; Jarzyna, M.; Considine, S.L.; Schneider, R.M.; Hittinger, C.T. Pathogenic Budding Yeasts Isolated Outside of Clinical Settings. FEMS Yeast Res. 2019, 19, foz032. [Google Scholar] [CrossRef]
- Souza, P.M.d.; Magalhães, P.d.O.e. Application of Microbial α-Amylase in Industry—A Review. Braz. J. Microbiol. 2010, 41, 850–861. [Google Scholar] [CrossRef]
- El-Fadaly, H.A.; El-Kadi, S.M.; Hamad, M.N.; Habib, A.A. Role of Fungal Enzymes in the Biochemistry of Egyptian Ras Cheese during Ripening Period. Open Access Libr. J. 2015, 2, e1819. [Google Scholar] [CrossRef]
- Ma, Y.; Wu, M.; Qin, X.; Dong, Q.; Li, Z. Antimicrobial Function of Yeast against Pathogenic and Spoilage Microorganisms via Either Antagonism or Encapsulation: A Review. Food Microbiol. 2023, 112, 104242. [Google Scholar] [CrossRef]
- Sasirekha, B.; Srividya, S. Siderophore Production by Pseudomonas aeruginosa FP6, a Biocontrol Strain for Rhizoctonia solani and Colletotrichum gloeosporioides Causing Diseases in Chilli. Agric. Nat. Resour. 2016, 50, 250–256. [Google Scholar] [CrossRef]
- Hranilovic, A.; Gambetta, J.M.; Schmidtke, L.; Boss, P.K.; Grbin, P.R.; Masneuf-Pomarede, I.; Bely, M.; Albertin, W.; Jiranek, V. Oenological Traits of Lachancea thermotolerans Show Signs of Domestication and Allopatric Differentiation. Sci. Rep. 2018, 8, 14812. [Google Scholar] [CrossRef] [PubMed]
- Zhou, N.; Ishchuk, O.P.; Knecht, W.; Compagno, C.; Piškur, J. Improvement of thermotolerance in Lachancea thermotolerans using a bacterial selection pressure. J. Ind. Microbiol. Biotechnol. 2019, 46, 133–145. [Google Scholar] [CrossRef]
- Wehner, J.; Mittelbach, M.; Rillig, M.C.; Verbruggen, E. Specialist Nectar-Yeasts Decline with Urbanization in Berlin. Sci. Rep. 2017, 7, 45315. [Google Scholar] [CrossRef]
- Colda, A.; Bossaert, S.; Verreth, C.; Vanhoutte, B.; Honnay, O.; Keulemans, W.; Lievens, B. Inoculation of Pear Flowers with Metschnikowia reukaufii and Acinetobacter nectaris Enhances Attraction of Honeybees and Hoverflies, but Does Not Increase Fruit and Seed Set. PLoS ONE 2021, 16, 0250203. [Google Scholar] [CrossRef]
- Guan, N.; Li, J.; Shin, H.d.; Du, G.; Chen, J.; Liu, L. Microbial Response to Environmental Stresses: From Fundamental Mechanisms to Practical Applications. Appl. Microbiol. Biotechnol. 2017, 101, 3991–4008. [Google Scholar] [CrossRef]
- Serra-Cardona, A.; Canadell, D.; Ariño, J. Coordinate Responses to Alkaline pH Stress in Budding Yeast. Microb. Cell 2015, 2, 182. [Google Scholar] [CrossRef]
- Mažeika, K.; Šiliauskas, L.; Skridlaitė, G.; Matelis, A.; Garjonytė, R.; Paškevičius, A.; Melvydas, V. Features of Iron Accumulation at High Concentration in Pulcherrimin-Producing Metschnikowia Yeast Biomass. J. Biol. Inorg. Chem. 2021, 26, 299–311. [Google Scholar] [CrossRef]
- El-Banna, A.A.; El-Razek, A.M.A.; El-Mahdy, A.R. Some Factors Affecting the Production of Carotenoids by Rhodotorula glutinis var. glutinis. Food Nutr. Sci. 2012, 3, 64–71. [Google Scholar] [CrossRef]
- Zeidan, R.; Ul-Hassan, Z.; Al-Thani, R.; Balmas, V.; Jaoua, S. Application of Low-Fermenting Yeast Lachancea thermotolerans for the Control of Toxigenic Fungi Aspergillus parasiticus, Penicillium verrucosum and Fusarium graminearum and Their Mycotoxins. Toxins 2018, 10, 242. [Google Scholar] [CrossRef]
- Bajaj, B.K.; Raina, S.; Singh, S. Killer Toxin from a Novel Killer Yeast Pichia kudriavzevii RY55 with Idiosyncratic Antibacterial Activity. J. Basic Microbiol. 2013, 53, 645–656. [Google Scholar] [CrossRef]
- Meneghin, M.C.; Reis, V.R.; Ceccato-Antonini, S.R. Inhibition of Bacteria Contaminating Alcoholic Fermentations by Killer Yeasts. Braz. Arch. Biol. Technol. 2010, 53, 1043–1050. [Google Scholar] [CrossRef]
- Roostita, L.B.; Fleet, G.H.; Wendry, S.P.; Apon, Z.M.; Gemilang, L.U. Determination of Yeasts Antimicrobial Activity in Milk and Meat Products. Adv. J. Food Sci. Technol. 2011, 3, 442–445. [Google Scholar]
- Clinical and Laboratory Standards Institute. Performance Standards for Antimicrobial Susceptibility Testing. In CLSI Supplement M100 ([Electronic]); Clinical and Laboratory Standards Institute: Wayne, PA, USA, 2021; ISBN 978-1-68440-105-5. [Google Scholar]
- De Clercq, V.; Roelants, S.L.K.W.; Castelein, M.G.; De Maeseneire, S.L.; Soetaert, W.K. Elucidation of the Natural Function of Sophorolipids Produced by Starmerella bombicola. J. Fungi 2021, 7, 917. [Google Scholar] [CrossRef]
- Aalamifar, H.; Soltanian, S.; Vazirzadeh, A.; Akhlaghi, M.; Morshedi, V.; Gholamhosseini, A.; Torfi Mozanzadeh, M. Dietary Butyric Acid Improved Growth, Digestive Enzyme Activities and Humoral Immune Parameters in Barramundi (Lates calcarifer). Aquac. Nutr. 2020, 26, 156–164. [Google Scholar] [CrossRef]
- Graff, S.; Chaumeil, J.-C.; Boy, P.; Lai-Kuen, R.; Charrueau, C. Influence of pH Conditions on the Viability of Saccharomyces boulardii Yeast. J. Gen. Appl. Microbiol. 2008, 54, 221–227. [Google Scholar] [CrossRef]
- Fernández-Pacheco, P.; Pintado, C.; Briones Pérez, A.; Arévalo-Villena, M. Potential Probiotic Strains of Saccharomyces and Non-Saccharomyces: Functional and Biotechnological Characteristics. J. Fungi 2021, 7, 177. [Google Scholar] [CrossRef]
- Silva, T.; Reto, M.; Sol, M.; Peito, A.; Peres, C.M.; Peres, C.; Malcata, F.X. Characterization of Yeasts from Portuguese Brined Olives, with a Focus on Their Potentially Probiotic Behavior. LWT-Food Sci. Technol. 2011, 44, 1349–1354. [Google Scholar] [CrossRef]
- Benito, S. The Impacts of Lachancea thermotolerans Yeast Strains on Winemaking. Appl. Microbiol. Biotechnol. 2018, 102, 6775–6790. [Google Scholar] [CrossRef]
- Fiori, S.; Urgeghe, P.P.; Hammami, W.; Razzu, S.; Jaoua, S.; Migheli, Q. Biocontrol Activity of Four Non- and Low-Fermenting Yeast Strains against Aspergillus carbonarius and Their Ability to Remove Ochratoxin A from Grape Juice. Int. J. Food Microbiol. 2014, 189, 45–50. [Google Scholar] [CrossRef]
- Bleve, G.; Grieco, F.; Cozzi, G.; Logrieco, A.; Visconti, A. Isolation of Epiphytic Yeasts with Potential for Biocontrol of Aspergillus carbonarius and A. niger on Grape. Int. J. Food Microbiol. 2006, 108, 204–209. [Google Scholar] [CrossRef] [PubMed]

| Strain | Biolog Microbial ID System | Bruker MALDI-TOF | PCR-RFLP Profile on of ITS1-5.8SrDNA-ITS2 Region | Sanger Sequencing of ITS1-5.8SrDNA-ITS2 Region |
|---|---|---|---|---|
| ST1 | C. vanderwaltii | No id | C. vanderwaltii/S. bombi | S. bombi |
| ST8.1 | M.reukaufii | No id | M. reukaufii | Nd |
| ST8.2 | Candida magnoliae | No id | C. magnoliae | S. (C.) magnoliae |
| ST10 | M. reukaufii | No id | M. reukaufii | Nd |
| ST12 | Scheffersomyces (Pichia) stipitis | No id | S.(P.) stipites/L. thermotolerans | L. thermotolerans |
| ST19 | K. (P.) ohmeri | No id | K. (P.) ohmeri | K. (P.) ohmeri |
| ST21.1 | M. reukaufii | No id | M. reukaufii | Nd |
| ST21.2 | M. reukaufii | No id | M. reukaufii | Nd |
| ST53 | P. membraniefaciens | C. valida | P. membraniefaciens | P. membraniefaciens |
| Strain | Caseinases | Amylases | Gelatinases | Hemolysins | Phospholipases | Siderophores | DN-Ase |
|---|---|---|---|---|---|---|---|
| S. bombi CMGB-ST1 | − | W | − | − | − | D | − |
| L. thermotolerans CMGB-ST12 | − | + | − | − | − | − | D |
| M. reukaufii CMGB-ST8.1 | + | + | − | − | − | + | − |
| C. magnoliae CMGB-ST8.2 | − | + | − | − | − | W | − |
| M. reukaufii CMGB-ST10 | + | + | − | − | − | + | W |
| K. ohmeri CMGB-ST19 | − | + | − | − | − | D | D |
| P. membranaefaciens CMGB-ST53 | − | − | − | − | − | − | − |
| M. reukaufii CMGB-ST21.1 | + | + | − | − | − | + | − |
| M. reukaufii CMGB-ST21.2 | − | + | − | − | − | + | D |
| Strain | C. parapsilosis CBS 604 | C. parapsilosis CMGBY3 | C. krusei CMGB 94 | C. krusei CMGB-Y8 | C. catenulata CMGB-Y7 | C. albicans ATCC10231 | C. albicans CMGB-Y12 | |
|---|---|---|---|---|---|---|---|---|
| S. bombi CMGB-ST1 | 3 days | − | − | + | − | − | − | − |
| 7 days | − | − | − | − | − | − | − | |
| L. thermotolerans CMGB-ST12 | 3 days | − | − | − | − | − | − | − |
| 7 days | − | − | − | − | + | − | − | |
| M. reukaufii CMGB-ST8.1 | 3 days | − | − | − | − | − | − | − |
| 7 days | + | − | + | − | − | − | − | |
| C. magnoliae CMGB- ST8.2 | 3 days | − | − | + | − | − | − | − |
| 7 days | + | − | + | − | − | − | − | |
| K. ohmeri CMGB-ST19 | 3 days | − | − | − | − | − | − | − |
| 7 days | ++ | − | − | − | + | − | − | |
| P. membranaefaciens CMGB-ST53 | 3 days | − | − | − | − | − | − | − |
| 7 days | ++ | − | + | − | − | − | − | |
| M. reukaufii CMGB-ST21.2 | 3 days | − | − | − | − | − | − | − |
| 7 days | ++ | − | + | − | − | − | − | |
| M. reukaufii CMGB-ST21.1 | 3 days | − | − | − | − | − | − | − |
| 7 days | + | − | − | − | − | − | − | |
| Strains | C. parapsilosis CBS 604 | C. parapsilosis CMGBY3 | C. krusei CMGB94 | C. krusei CMGB Y8 | C. catenulata CMGB-Y7 | C. albicans ATCC 10231 | C. albicans CMGB-Y12 | |
|---|---|---|---|---|---|---|---|---|
| S. bombi CMGB-ST1 | 3 days | − | ++ | + | − | − | + | + |
| 7 days | − | ++ | ++ | − | − | + | ++ | |
| L. thermotolerans CMGB-ST12 | 3 days | − | − | − | − | − | + | + |
| 7 days | − | − | − | − | − | + | − | |
| M. reukaufii CMGBST8.1 | 3 days | − | − | + | ++ | − | + | − |
| 7 days | − | − | + | ++ | − | + | − | |
| C. magnoliae CMGB- ST8.2 | 3 days | − | − | + | ++ | − | − | − |
| 7 days | − | + | + | + | − | − | − | |
| M. reukaufii CMGB-ST10 | 3 days | − | − | + | ++ | − | + | − |
| 7 days | − | − | + | ++ | − | + | − | |
| K. ohmeri CMGB-ST19 | 3 days | − | − | + | + | − | + | + |
| 7 days | − | + | + | +++ | − | + | − | |
| P. membranaefaciens CMGB-ST53 | 3 days | − | − | − | − | − | − | − |
| 7 days | − | − | − | − | − | − | − | |
| M. reukaufii CMGB-ST21.1 | 3 days | − | − | + | + | − | − | − |
| 7 days | − | − | + | + | − | − | − | |
| M. reukaufii CMGB-ST21.2 | 3 days | − | − | + | ++ | − | + | − |
| 7 days | − | − | + | ++ | − | + | − | |
| Strains | S. typhimurium ATCC14028 | L. monoxytogenes CMGB333 | B. cereus CMGB 53-100 | E. coli ATCC 259-22 | P. aeruginosa ATCC 27853 | S. aureus ATCC6538 |
|---|---|---|---|---|---|---|
| S. bombi CMGB-ST1 | − | S | S | + | + | S |
| L. thermotolerans CMGB-ST12 | − | S | S | − | − | S |
| M. reukaufii CMGB-ST8.1 | − | S | S | W | W | S |
| C. magnoliae CMGB-ST8.2 | W | S | S | + | + | S |
| M. reukaufii CMGB-ST10 | − | S | S | − | − | S |
| K. ohmeri CMGB-ST19 | − | S | S | − | − | S |
| P. membranaefaciens CMGB-ST53 | − | S | S | − | − | S |
| M. reukaufii CMGB-ST21.1 | − | S | S | − | ++ | S |
| M. reukaufii CMGB-ST21.2 | − | S | S | − | + | S |
| Strains | 20 °C | 28 °C | 37 °C | |||
|---|---|---|---|---|---|---|
| 4 Days | 7 Days | 4 Days | 7 Days | 4 Days | 7 Days | |
| S. bombi CMGB-ST1 | + | ++ | +++ | +++ | + | + |
| L. thermotolerans CMGB-ST12 | W | + | + | + | + | + |
| M. reukaufii CMGB-ST8.1 | − | W | + | + | − | − |
| C. magnoliae CMGB-ST8.2 | − | W | + | + | − | − |
| M. reukaufii CMGB-ST10 | W | + | + | + | W | + |
| K. ohmeri CMGB-ST19 | W | + | + | + | + | + |
| P. membranaefaciens CMGB-ST53 | W | + | + | + | − | − |
| M. reukaufii CMGB-ST21.1 | W | + | + | + | W | − |
| M. reukaufii CMGB-ST21.2 | W | + | + | + | W | − |
| Strains | S. boulardii CMGB-S | K. marxianus CMGB159 | K. lactis CMGB112 | S. salivarius ATCC 19258 | Lb. acidophilus ATCC 4356 | |||
|---|---|---|---|---|---|---|---|---|
| 3 Days | 7 Days | 3 Days | 7 Days | 3 Days | 7 Days | 1 Day | 1 Day | |
| S. bombi CMGB-ST1 | − | − | − | − | − | − | − | − |
| L. thermotolerans CMGB-ST12 | − | − | − | − | − | − | − | − |
| M. reukaufii CMGBST8.1 | + | + | + | ++ | − | − | − | − |
| C. magnoliae CMGB-ST8.2 | ++ | ++ | ++ | ++ | − | + | − | − |
| M. reukaufii CMGB-ST10 | + | ++ | + | ++ | − | − | − | − |
| K. ohmeri CMGB-ST19 | − | − | − | − | − | − | − | − |
| P. membranaefaciens CMGB-ST53 | − | − | − | − | − | − | − | − |
| M. reukaufii CMGB-ST21.1 | + | − | + | − | − | − | − | − |
| M. reukaufii CMGB-ST21.2 | ++ | ++ | + | − | − | − | − | − |
| Strains | B. cinereea | A. ochraceus | R. solani | A. flavus T11 | A. flavus GE2 | A. flavus GIS2 | A. flavus GIS9 |
|---|---|---|---|---|---|---|---|
| S. bombi CMGB-ST1 | + | + | − | + | + | − | + |
| L. thermotolerans CMGB-ST12 | + | + | − | − | − | − | + |
| M. reukaufii CMGB-ST8.1 | + | − | − | + | + | + | + |
| C. magnoliae CMGB-ST8.2 | + | + | + | + | + | + | + |
| M. reukaufii CMGB-ST10 | + | + | − | − | − | − | + |
| K. ohmeri CMGB-ST19 | + | + | − | + | + | − | + |
| P. membranaefaciens CMGB-ST53 | + | − | + | + | + | + | |
| M. reukaufii CMGB-ST21.1 | + | + | − | + | + | − | + |
| M. reukaufii CMGB-ST21.2 | + | + | − | + | + | + | + |
Disclaimer/Publisher’s Note: The statements, opinions and data contained in all publications are solely those of the individual author(s) and contributor(s) and not of MDPI and/or the editor(s). MDPI and/or the editor(s) disclaim responsibility for any injury to people or property resulting from any ideas, methods, instructions or products referred to in the content. |
© 2024 by the authors. Licensee MDPI, Basel, Switzerland. This article is an open access article distributed under the terms and conditions of the Creative Commons Attribution (CC BY) license (https://creativecommons.org/licenses/by/4.0/).
Share and Cite
Corbu, V.M.; Dumbravă, A.Ș.; Gheorghe-Barbu, I.; Csutak, O. Epiphytic Yeasts from South Romania for Preventing Food Microbial Contamination. Life 2024, 14, 1087. https://doi.org/10.3390/life14091087
Corbu VM, Dumbravă AȘ, Gheorghe-Barbu I, Csutak O. Epiphytic Yeasts from South Romania for Preventing Food Microbial Contamination. Life. 2024; 14(9):1087. https://doi.org/10.3390/life14091087
Chicago/Turabian StyleCorbu, Viorica Maria, Andreea Ștefania Dumbravă, Irina Gheorghe-Barbu, and Ortansa Csutak. 2024. "Epiphytic Yeasts from South Romania for Preventing Food Microbial Contamination" Life 14, no. 9: 1087. https://doi.org/10.3390/life14091087
APA StyleCorbu, V. M., Dumbravă, A. Ș., Gheorghe-Barbu, I., & Csutak, O. (2024). Epiphytic Yeasts from South Romania for Preventing Food Microbial Contamination. Life, 14(9), 1087. https://doi.org/10.3390/life14091087

